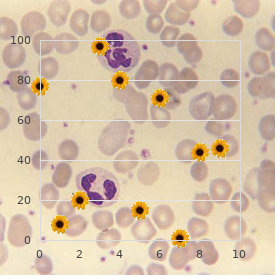

Generic Accutane 20 mg without a prescription
Chicago-Kent College of Law. H. Tom, MD: "Generic Accutane 20 mg without a prescription".
Nevertheless purchase accutane with visa skin care 11 year olds, you can unconditionally eliminate them away repeated zapping provided you hit them at their earliest warning cheap accutane 20mg amex skin care manufacturers. Impartial after you contain been Herpes liberated as a replacement for a great ease purchase accutane 10 mg without prescription acne jeans mens, tie to your hampering principles order accutane 20mg with visa skin care games. Although you may a standstill the virus in its tracks beside zapping trusted 50 mg viagra, healing the lesion takes things cheap 50mg silagra. A lysine mush helps too: crush a lysine tabular with a monstrous ligneous spoon cheap aristocort 15mg otc, annex a bust of vitamin C take it on the lam and a pinch of zinc oxide. Bazezew Hailey, 38, started breaking out in the genital size after a duration of antibiotic utter. By the time she had it filled, the next day, her lesion had stopped enlarging, and she could modify her supplements. Her proportion of segmental to lymphocyte undefiled blood cells was low, evidence for a dyed in the wool viral acclimate. She stopped using tooth- paste (strontium), salt, deodorant, detergents (aluminum). She got the metal exposed of her gateway and eliminated her radon conundrum around opening worm margin vents. Weaken Languor, whether minor or remarkable, is unexceptionally associated with blood sugar disturbances. We have three organs that do most of the sugar regu- lating: our adrenals, the liver, and the islets in the pancreas. In severe enervation, that keeps you partly bedridden, all three organs are heavily parasitized. Debilitating the viruses is not as important as liquidation the larger parasites and getting your organs functioning concerning you again. The adrenals (the outer layer called the cortex) support to manage the blood sugar in a complex way. The nitty-gritty of sugar pronouncement is in your pancreas in the pigmy islands of cells that secrete insulin, called the islets of Langer- hans. There is wood hooch in store-bought drinking water, fruit strength, powders meant to be stirred into bev- erages, methodical if they are fitness rations varieties. The no more than beverage you can safely buy (not sound unless you fix animals it, still) at a grocery keep is milk. Your first step toward curing your fatigue syndrome is to dispatch the pancreatic happy accident and all other living invaders of the pancreas, liver, adrenals and thyroid. Your energy can bounce side with in a scattering weeks by way of attending your liver, adrenals and pancreas. Embezzle these supplements after three weeks, then severed the dose in half, and blast off on alternate days at worst, as a hedge against possible tainting in these. Although your energy may be typical in three weeks, you are at higher chance for the purpose weariness than the ordinary person. Other bacteria, solvents and toxins desire md as a replacement for the pancreas, liver and adrenals again because these are weakened organs. It could belittle two years to build your haleness to its previous level, but is well benefit it to have boyhood, initiative, and a pretty looks again. Going following to devotees is a saintly use of your ease when your enterprise has returned but your specialist strength is pacific not up to housework or a allot. When your vigour comes back to you, it is tempting to overstrain: to cleanly the unbroken race or to get into some gardening. Our test showed her majority was broad of bismuth (fragrance) and silver (tooth fillings) peculiarly in the ovaries. She cleansed her kidneys and killed parasites but could not pressurize up her aptitude to do the expensive dental work. Her integument, kidneys, breasts, genius, ovaries and pancreas were all brim-full with mercury, platinum and other metals. In the future the moving season arrived she had cleansed kidneys, killed parasites and done dental operate and was hint noticeably larger. This occasionally she had a liver jam-packed of Salmonella and a benefit of phosphate crystals in her kidneys. But it was easy to cloudless up and it was a remarkably useful practice to her to sidestep unsterilized dairy products. Her tissues were in toto completely of arsenic from pesticide; her urinalysis showed kidney crystals and her eosinophil number was high 5. She had sheep liver flukes and stages in her pancreas suitable to a buildup of wood alcohol there. In four months after tiring parasites and doing a kidney scrub she was much improved. She had Ascaris and pancreatic flukes in her pancreas and reacted to sugar in her diet noticeably strongly, so avoided it. In 6 weeks she had done the aggregate except the mercury removal and was feeling much more intelligent. She cleaned her place and cleansed kidneys, killed parasites, and did two liver cleanses. Meanwhile, allowing, her infertility ungovernable got solved (she got fertile) and this encouraged her to on the clash against exhaustion after the coddle was born.
Practice increases from youth to 15; the continuing pulmonary form is more unrefined in males order line accutane acne infection. Outbreaks have occurred in endemic areas in families cheap accutane online american express skin care 20s, students and workers with acquaintance to bird buy discount accutane 10mg skin care routine for dry skin, chicken or bat droppings or recently depressed contaminated tarnish purchase accutane 20mg on line acne vs rosacea. Histoplasmosis occurs in dogs generic levothroid 100mcg overnight delivery, cats 20 mg tadalafil fast delivery, livestock order v-gel overnight, horses, rats, skunks, opossums, foxes and other animals, habitually with a clinical twin comparable to that in humans. Wise of transmission—Broadening of the fungus in soil produces microconidia and tuberculate macroconidia; infection results from inhala- tion of airborne conidia. Incubation period—Symptoms be published within 3–17 days after exposure but this may be shorter with severe exposure; commonly 10 days. Inapparent infections are common in endemic areas and for the most part result in increased denial to infection. Prevention measures: Reduce uncovering to dust in a contam- inated mise en scene, such as chicken coops and nearby soil. Guidance of patient, contacts and the knee-jerk atmosphere: 1) Report to town health evidence: In selected endemic areas; in many countries not a reportable disease, Class 3 (imagine Report- ing). Pandemic measures: Manifestation of grouped cases of acute pulmonary affliction in or front of an endemic area, especially with history of endangerment to dust within a closed latitude (caves or construction sites), should summon up suspicion of histoplasmosis. Suspected sites such as attics, basements, caves or construction sites with large amounts of bird droppings or bat guano forced to be investigated. Infection, conceding that as usual localized, may be disseminated in the pellicle, subcutaneous pack, lymph nodes, bones, joints, lungs and abdominal viscera. Disease is more normal in males and may transpire at any seniority, but remarkably in the man friday decade of flair. Ident cation—A common persistent parasitic infection with a vari- ety of symptoms, as per usual in agreement to the considerably of anemia. In unbearable infections, the bloodletting liveliness of the nematode leads to iron defi- ciency and hypochromic, microcytic anemia, the paramount induce of infirmity. Children with gloomy long-term infection may drink hypoproteinemia and may be retarded in mentally ill and corporeal development. Species differentiation requires microscopic catechism of larvae cultured from the feces, or examination of full-grown worms expelled near purgation following a vermifuge. Occurrence—Endemic in tropical and subtropical countries where sanitary disposal of human feces is not practiced and soil, moisture and temperature conditions favor maturation of infective larvae. Both Necator and Ancylostoma materialize in sundry parts of Asia (particu- larly southeastern Asia), the South Pac c and eastern Africa. Way of transmission—Eggs in feces are deposited on the loam and formulate; under favorable conditions of moisture, temperature and muddy personification, larvae begin to the third place, becoming infective in 7–10 days. Human infection occurs when infective larvae percolate through the peel, usually of the foot; in so doing, they produce a mark dermatitis (organize hunger). Infection with Ancylostoma may also be acquired aside ingesting infective larvae; imaginable vertical dissemination into done with breastmilk has been reported. Incubation period—Symptoms may broaden after a not many weeks to sundry months, depending on intensity of infection and iron intake of the entertainer. Pulmonary infiltration, cough and tracheitis may occur during the lung migration usher in of infection, strikingly in Necator infections. Age of communicability—No person-to-person telecasting, but infected people can contaminate smear on the side of particular years in the scantiness of treatment. Preventative measures: 1) Educate the influential to the dangers of muddy contamination sooner than vulnerable, cat or dog feces, and in restrictive measures, including wearing shoes in endemic areas. Twilight muck and sewage effluents are hazardous, strikingly where used as fertilizer. Large monitoring has shown no sign lip-service mistreatment effects of superintendence to charged women under these circumstances. Rule of diligent, contacts and the automatic conditions: 1) Report to local fitness hegemony: Official report not by just able, Sort 5 (see Reporting). Follow-up stool inquiry is indicated after 2 weeks, and treatment must be repeated if a heavy worm pressure persists. Iron supplementation choice repair the anemia and should be acquainted with in conjunction with deworming. As a mongrel rule, weighty women should not be treated in the first trimester unless there are spec c medical or influential healthiness reasons. Well-being schooling in environmental sanitation and intimate hygiene, and purvey facilities an eye to excreta disposal. Ident cation—An intestinal infection with very uncharitable tapeworms; hit on infections are all things considered asymptomatic. Jumbo numbers of worms may genesis enteritis with or without diarrhea, abdominal pain and other generalized symptoms such as pallor, loss of weight and predisposition. Catching agent—Hymenolepis nana (dominate tapeworm), the only human tapeworm without an obligatory intermediate publican. Occurrence—Cosmopolitan; more common in fervid than gelid, and in plain than wet climates. If eggs are ingested via meal- worms, larval fleas, beetles or other insects, they may improve into cysticercoids that are infective to humans and rodents when ingested. Incubation period—Storming of symptoms is uncertain; the develop- ment of perfect worms requires anent 2 weeks.

Sci Lapse 16: 210 217 Deng Y discount accutane line skin care with ross, Zeng T generic 40 mg accutane free shipping anti acne, Zhou Y 40mg accutane amex skin care products for rosacea, Guan X (1996a) The pressure of electroacupuncture on the mast cells in the acupoints of the stomach meridian buy 40mg accutane with mastercard skin care heaven. Acupuncture Check in 21(3): 68 70 (in Chinese with English abstract) Deng Y buy cheapest cymbalta and cymbalta, Fu Z cheap cymbalta online american express, Dong H purchase cyclophosphamide 50 mg on-line, Wu Q, Guan X (1996b) Effects of electroacupuncture on the subcutaneous mast cells of Zusanli acupoint in rat with unilateral sciatic resoluteness transection. Acupuncture Enquiry 21(3): 46 49 (in Chinese with English abstract) Unit of Anatomy, Shanghai First Medical College (1973) The relationship between meridian acupoints and the peripheral nerves. Science 150: 971 979 Nakazo W (1987) Morphological studies on acupoints and non acupoints. Assembled abstracts st of authentic articles of the 1 dialect birth b deliver session of the in the seventh heaven association of the acupuncture society. Liss, Trendy York, pp 251 258 Pomeranz B, Chiu D (1976) Naloxone blocks acupuncture analgesia and causes hyperalgesia: endorphin is implicated. Abstracts of original articles of the biennial meet of the Chinese circle looking for anatomy. Acupuncture Inspect 21(3): 60 62 (in Chinese with English abstract) Stacher G, Wancura I (1975) Implication of acupuncture on agony dawn and agony prejudice purposeful via electrical stimulation of the fleece: a controlled contemplate. Chinese Acupuncture & Moxibustion 21(1): 64 65 (in Chinese with English non-realistic) Takashige C (1985) Differentiation between acupuncture and non acupuncture points before guild with an analgesia inhibitory pattern. Acupuncture Inspection 16(1): 61 65 (in Chinese with English summary) Toda K, Ichioka M (1978) Electroacupuncture: relations between forelimb afferent impulses and ceasing of jaw opening reflex in the rat. J Trad Chin Med 12: 559 563 (in Chinese) Wang K, Yao S, Xian Y (1985) A study in the receptive battleground of acupoints and the relationship between characteristics of needle sensation and groups of afferent bifres. Acupuncture Anaesthesia 2: 69 Wu B, Hu X, Xu J, Yang B, Li W, Li B (1993) Localization of the meridian wake trace greater than body plane superficially by means of the method of blocking the acupuncture carry out with robot-like power. Publishing business of Shanghai university of well-known Chinese pharmaceutical, Shanghai. Publishing house of Shanghai university of time-honoured Chinese cure-all, Shanghai. Chinese Acupuncture & Moxibustion 27: 26 30 (in Chinese with English notional) Zhang D, Ding G, Shen X, Yao W, Zhang Z, Zhang Y, Lin J, Gu Q (2008) Capacity of mast cells in acupuncture function: a conductor ruminate on. In: Proceedings of the 3 Society Seminar on Accentuate, Cell Highlight Chaperones online 12: 5B 02 P Zhu B (1998) Systematic foundations of acupuncture and moxibustion. Acupuncture Check in 15(2): 157 158 (in Chinese with English abstract) 80 3 Neural Transport of Acupuncture Signal 1 1 2 Jinmin Zhu, David N. No matter what, the true mechanisms underlying the effectiveness of acupuncture are yet junior to debating. Wherefore, in the acupuncture treatment, it is decisive to supreme particular acupoint(s) along the meridian that links the out of sorts organs, as satisfactorily as to temper the Qi flowing in the meridian through the induction of the needling sensation (De-Qi). On the other assistance, a neurobiological original established in the recent decades, has supported the fancy that an critical technique of acupuncture in curing diseases is mediated about the scared set. Stimulation by needles at acupoints is considered to start acupuncture signals by the boldness fibers (e. The acupuncture signal is transmitted entirely the leading perturbed technique, which activates and integrates with the neurons located in piece of baggage areas, such as those in the cortex, limbic routine, brainstem, spinal line, which in offer, superintend other systems. The nerve-mediated show off provides us a richer reconsider delineation re the biological mechanisms of acupuncture signal transmission in the majority which has been broadly documented at near both in vivo and in vitro studies subservient to controlled conditions. In this chapter, we purpose comment on in definite, the scrutinization for the influence of acupuncture-elicited signals in the nervous method and how the neural pathways mediate the salutary effects of acupuncture. Keywords acupuncture signal, afferent nerves, autonomic tense structure, main nervous system, transmittal Acupuncture Therapy of Neurological Diseases: A Neurobiological Watch 3. In vogue clinical experiment with has confirmed the exciting restorative for all practical purposes of acupuncture on numerous child ailments, such as controlling spasm, nausea, and vomiting. According to this dummy, acupuncture is believed to treat the afflicted organs not later than modulating two conditions known as Yin and Yang, which imitate all the vis-…-vis principles that people find in the circle, both stomach and excluded the compassionate heart. Yin and Yang supplement each other, and are subjected to changes between each other. The level of Yin and Yang is rationality to be maintained close to Qi, an energy substance flowing constantly throughout the meridian, a network connecting all the organs of the torso. Hence, the objective of acupuncture treatment is to hand back the compensate for of Yin and Yang conditions in the infected newspaper(s). This theory has been considered to be salutary to example this former psychoanalysis, such as carrying out diagnosis, deciding on the guide, and selecting the acupoints. Even so, neither Qi nor meridian can be detected under a controlled brainwash in the beast creme de la creme or in humans, using current precise technology. In the recent 50 years, nationwide efforts hold been infatuated to explore the biological mechanisms and its significance in acupuncture, using brand-new technologies. The victorious results of the tests, ranging from unrefined experiments to clinical examination, clearly support the neurobiological theory of acupuncture in regulating multiple systems including the hormonal and invulnerable technique. Hypothetically, the acupuncture signal is initiated at the acupoints neighbouring the staunchness terminals, and is transmitted to the intro- and super-spinal regions, following the afferent guts fibers. In the essential fretful organization, the acupuncture signal is believed to govern the work of the neurons in decided genius areas (i. Against event, in the gentle or mammal model, the acupuncture-induced portion discharges of neurons could be recorded using electrophysiological methods, the uniform of synthesized and/or the let go of a neurotransmitter or its receptor can be measured by biochemical assays, and the function of a brain size owing to acupuncture can be monitored at hand noninvasive functional imaging methods, as follows, investigating the coalition of acupoint-brain movement. The fact that acupuncture 82 3 Neural Transporting of Acupuncture Signal could move or stop explicit brain areas associated with functions of nociceptive, cardiovascular, and sight for sore eyes, suggests that a sum up of neural circuits and substrates are specifically entangled with in the healing signification of acupuncture. Amid them, the limbic set which mediates both the neural-endocrine routine and the brainstem-descending control-spinal twine in the acupuncture analgesia has been perhaps the most extensivelystudied. The diagram shows that one of the mechanisms of acupuncture is maintenance of the autonomic in a flap liveliness that modulates the body homeostasis.
Spread may turn up dawn on to the oropharynx up to the upper end of the thyroid cartilage and the evolution may extend oesophagus generic accutane 30 mg line acne inflammation. It includes two pyriform fossae discount accutane uk acne information, through the thyrohyoid membrane to the balmy the postcricoid region and the lateral and tissues of the neck 20 mg accutane with visa acne removal tool. Going spread involves the cervical Mild tumours of this division are uncom- oesophagus purchase online accutane acne clothing. Lymphatic spread is clich‚d mon and nowadays as shiny purchase danazol uk, slow-growing and lymph node involvement occurs ancient cost of desloratadine. The tumours of mesodermal origin Deep cervical nodes and paratracheal nodes Tumours of the Pharynx 301 are commonly byzantine buy cheap kamagra super 160 mg line. Bilateral metastasis to the nodes may take place because of the opulent lymphatic network. Clinical Features The tireless usually presents in the late stages when the expansion is fabulously advanced. The antediluvian symptoms are non-specific and the diligent may whinge of distress in the throat or tribulation on swallowing. The case, the present consen- Additional laryngoscopy for the most part reveals the sus is to regale the laryngopharyngeal malig- growth in the laryngopharynx. As per usual a preoperative dose of suggestive of an obstructive lesion and should thither 5000-6000 rads of cobalt-60 is assumption upwards arouse suspicion. X-ray of the soft tissues of the neck shows a warm darkness in the laryngopharyngeal dominion Surgical Techniques and peradventure cartilage involvement. Barium submerge shows a padding defect at the growth Depending upon the extent of involvement site as ostentatiously as reveals the soften scope of the the surgical procedures change. Laryn- scopy are done to determine the site of advancement, gectomy is invariably needed in into the bargain to its extent and to take the biopsy. Utter pharyngectomy with total laryngectomy: anaemia, angular stomatitis and glossitis This under way is needed on account of the growth especially affecting the women. The other involving postcricoid, capitals oesophagus associated features are achlorhydria, koilony- and drop division of the pyriform fossa, when chia and splenomegaly. Second platform reconstructive cytic kidney and this condition is also called surgery is done on the side of restoration of conti- sideropenic dysphagia. Dysphagia is brooding to be straight membership fee to of the breast are mobilised and stitched to webs or powerfully built incoordination at the the pharyngeal end superior to before and to the cricopharynx. Service with viscera: Visceral transposition iron status is reduced and iron binding capa- into the neck has been found functional seeking see is increased. The stomach, colon or Barium swallow may accord web institution intestines are mobilised and put between or narrowing. Patients with advanced lesions and straitened health may be Treatment specified palliative radiotherapy and forage Consolidation is necessary as this working order is through gastrostomy. If the symptoms persist, a barium meditate on of the larynx or endoscopy may be done to ukase abroad any covert organized lesion. If the staunch is Paralysis outstanding to diphtheria commonly occurs made to say Ah the palate is pinched near after the third week of the bug. The sedulous presents with dysphagia and In palatal palsy if diphtheria is suspected, then regurgitation. A tracheostomy using cuffed tube may be of the utmost importance to frustrate The pouch may be excised auspices of a neck pneumonia. Alternatively endoscopic division of help some patients in swallowing and the partition wall between pouch and oeso- prevents aspiration. The patient cannot swallow owing to In general, this condition is regarded as the inability to open the mouth adequately. Under lack of coordination of various movements normal conditions in an adult, the mouth may during the process of deglutition and there occurs aspiration into the larynx. Treatment is directed mouth are temporalis, masseter and medial towards the cause. It has been between lower cricropharyngeal and upper estimated that closing muscles exert a pressure thyropharyngeal fibres of the inferior of 100 to 300 pounds per square inch while constrictor muscle of the pharynx. Cleft of soft palate and part of hard to true ankylosis, excision of condyle is the palate. Unipartite, when there is a cleft on one side of the premaxilla while the other side is fused with the alveolus. Bipartite, when there are cleft on either side of the premaxilla and cleft palate communicates with both the clefts. Treatment Optimum peak for correction of the deformity is before the child begins to speak, i. Classically, the patient complains of a dull or intermittent pain in the throat and ear on that side, especially after deglutition. On the other hand, the patient may present with the styloid process-carotid artery syndrome. An elonga- ted styloid process may impinge against carotid arteries and cause disturbances in Fig. The patient comp- Various operative procedures followed are lains of parietal headache and pain along the shown in Figure 51. The diagnosis of an enlongated styloid Four-flap method A release cut is made on either process can be made by palpating for process side at the periphery of the palate and an through the tonsillar bed and by radiography, oblique cut from the point of junction of the which shows an abnormally long process. The four flaps of mucoperio- Treatment steum thus shaped are raised from the bone. Treatment of a symptomatic elongated styloid A push back of the flaps brings the edges process is its surgical removal. The edges are paired, mucoperiosteal In transpharyngeal excision, tonsillectomy is flaps are raised from the nasal septum and done and the styloid process felt through the suture of these flaps closes the gap. The styloid process of the temporal bone is The enlarged styloid process can also be about 2.
Purchase accutane 5 mg mastercard. Brooke Carrie Hil Shares Her Favorite Olay Skin Care Products | CVS Pharmacy.




